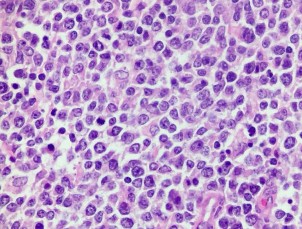
HE x 100 Tế bào u nhân lớn bào tương hẹp rời rạc HE x 400 Tế bào u nhân 5
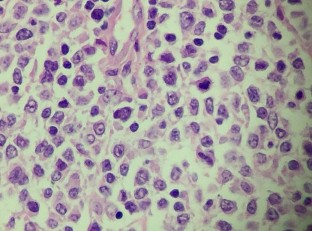
HE x 100 Tế bào u nhân lớn bào tương hẹp rời rạc HE x 400 Tế bào u nhân 6
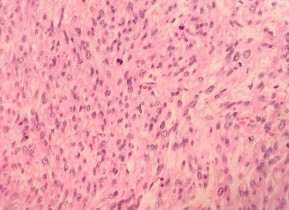
HE x 100 Các tế bào u hình thoi nhân bàu bào tương hồng sắp xếp thành bó HE x 10

(Bệnh nhân : Hoàng Đình T.)
| |
HE x 100: Tế bào u hình thoi, nhân lớn, rõ hạt nhân | HE x 400: U giàu nhân chia, bài tương giàu hạt sắc tố |
|
|
HE x 400: U giàu nhân chia, bài tương giàu hạt sắc tố | CHE x 400: U xâm nhập mạch bạch huyết |
Có thể bạn quan tâm!
-
Nghiên cứu đặc điểm lâm sàng, giải phẫu bệnh và kết quả điều trị ung thư ống tiêu hóa không thuộc biểu mô tại bệnh viện Việt Đức - 20 -
Nghiên cứu đặc điểm lâm sàng, giải phẫu bệnh và kết quả điều trị ung thư ống tiêu hóa không thuộc biểu mô tại bệnh viện Việt Đức - 21 -
U Cơ Vân Ác Tính (Rbahdomyosarcoma) (Bệnh Nhân: Phạm Văn T.) -
Nghiên cứu đặc điểm lâm sàng, giải phẫu bệnh và kết quả điều trị ung thư ống tiêu hóa không thuộc biểu mô tại bệnh viện Việt Đức - 24 -
Nghiên cứu đặc điểm lâm sàng, giải phẫu bệnh và kết quả điều trị ung thư ống tiêu hóa không thuộc biểu mô tại bệnh viện Việt Đức - 25
Xem toàn bộ 205 trang tài liệu này.
(Bệnh nhân : Bế Thị Lê C.)
| |
HE x 100: Tế bào u nhân lớn, bào tương hẹp, rời rạc | HE x 400: Tế bào u nhân lớn, bào tương hẹp, rời rạc |
|
|
CD20: Dương tính mạnh với màng bào tương | MUM1: Dương tính với nhân |
(Bệnh nhân: Triệu Tài V.)
| |
HE x 100: Các tế bào u hình thoi, nhân bàu, bào tương hồng, sắp xếp thành bó | HE x 400: Không rõ màng nhân, giàu nhân chia. |
|
|
SMA: Dương tính mạnh bào tương | DESMIN: Dương tính bào tương |
|
|
CALDESMON: Dương tính với bào tương | DOG 1: Âm tính với tế bào u |
DANH SÁCH BỆNH NHÂN
PHẪU THUẬT UNG THƯ ỐNG TIÊU HÓA KHÔNG THUỘC BIỂU MÔ TẠI BỆNH VIỆN HN VIỆT ĐỨC
Từ tháng 1/2009 đến tháng 4/2019
Họ và tên | Giới | Tuổi | Ngày vào | Ngày ra | Mã hồ sơ | |
1 | Lý Thành Tr. | Nam | 38 | 19/1/2009 | 11/2/2009 | 1937/C18 |
2 | Nguyễn Trọng H. | Nam | 64 | 13/2/2009 | 23/2/2009 | 3596/C45 |
3 | Nguyễn Cao B. | Nam | 62 | 17/2/2009 | 28/2/2009 | 34310/C18 |
4 | Vũ Van T. | Nam | 76 | 12/5/2009 | 26/5/2009 | 11859/C17 |
5 | Bùi Bảo T. | Nam | 53 | 25/5/2009 | 20/6/2009 | 13118/C16 |
6 | Dương Thị Q. | Nữ | 60 | 26/6/2009 | 10/7/2009 | 16326/C16 |
7 | Hoàng Thị V. | Nữ | 60 | 10/11/2009 | 9/12/2009 | 30572/C20 |
8 | Nguyễn Ánh T. | Nữ | 32 | 15/1/2010 | 29/1/2010 | 1283/C16 |
9 | Bạch Minh S. | Nam | 64 | 20/1/2010 | 28/1/2010 | 1726/C20 |
10 | Đặng Thanh H. | Nam | 63 | 9/3/2010 | 22/3/2010 | 5447/C16 |
11 | Nguyễn Thị T. | Nữ | 70 | 25/3/2010 | 5/4/2010 | 8177/C16 |
12 | Lê Hữu Ư. | Nam | 57 | 29/3/2010 | 6/4/2010 | 8543/C17 |
13 | Nguyễn Hùng T. | Nam | 63 | 12/4/2010 | 27/4/2010 | 8976/C45 |
14 | Dương Thanh H. | Nữ | 39 | 16/4/2010 | 4/5/2010 | 9547/C45 |
15 | Trần Hữu H. | Nam | 36 | 19/4/2010 | 28/4/2010 | 9743/C20 |
16 | Nguyễn Thị L. | Nữ | 85 | 22/4/2010 | 1/6/2010 | 10151/C16 |
17 | Cầu Ngọc H. | Nam | 62 | 4/5/2010 | 17/5/2010 | 11144/C16 |
18 | Đặng Thị M. | Nữ | 54 | 17/5/2010 | 28/5/2010 | 12506/C16 |
19 | Bùi Thị S. | Nữ | 47 | 8/6/2010 | 29/6/2010 | 14929/C45 |
20 | Trần Thị S. | Nữ | 67 | 10/7/2010 | 20/7/2010 | 18301/C45 |
21 | Trần Thị Ng. | Nữ | 42 | 30/7/2010 | 11/8/2010 | 20490/C16 |
22 | Vũ Thị T. | Nữ | 33 | 5/8/2010 | 10/9/2010 | 21176/C17 |
23 | Nguyễn Thị Nh. | Nữ | 65 | 12/8/2010 | 20/8/2010 | 2639/C16 |
24 | Dương Thị D. | Nữ | 60 | 19/8/2010 | 30/8/2010 | 23789/C16 |
25 | Nguyễn L. | Nam | 75 | 23/8/2010 | 1/9/2010 | 24025/C16 |
26 | Trịnh Văn Ph. | Nam | 50 | 1/9/2010 | 20/9/2010 | 25821/C16 |
27 | Nguyễn Văn Y. | Nam | 51 | 10/9/2010 | 21/9/2010 | 25896/C45 |
28 | Phạm Văn L. | Nam | 54 | 10/9/2010 | 24/9/2010 | 25892/C16 |
29 | Trịnh Thị C. | Nữ | 73 | 4/3/2010 | 25/3/2010 | 5107/C20 |
Nguyễn Thị S. | Nữ | 50 | 30/9/2010 | 22/10/2010 | 27989/C16 | |
31 | Lê Thị Nh. | Nữ | 62 | 12/10/2010 | 28/10/2010 | 29175/C16 |
32 | Ninh Thị Th. | Nữ | 23 | 22/10/2010 | 15/11/2010 | 30262/C16 |
33 | Đoàn Thị H. | Nữ | 33 | 29/10/2010 | 11/11/2010 | 31036/C16 |
34 | Đặng Yên Ch. | Nam | 76 | 17/11/2010 | 7/12/2010 | 33319/C17 |
35 | Lục Thị Th. | Nữ | 46 | 17/11/2010 | 26/11/2010 | 33104/C17 |
36 | Đoàn Công K. | Nam | 36 | 19/11/2010 | 3/12/2010 | 33310/C17 |
37 | Vũ Thị L. | Nữ | 63 | 23/11/2010 | 3/12/2010 | 33682/C16 |
38 | Vũ Tuấn M. | Nam | 69 | 15/12/2010 | 24/12/2010 | 36109/C17 |
39 | Trần Văn D. | Nam | 31 | 7/1/2011 | 24/1/2011 | 587/C48 |
40 | Bùi Thị M. | Nữ | 67 | 12/1/2011 | 26/1/2011 | 1041/C16 |
41 | Nguyễn Thị H. | Nữ | 74 | 28/2/2011 | 18/3/2011 | 4742/c16 |
42 | Ngô Doãn H. | Nam | 38 | 22/3/2011 | 1/4/2011 | 6897/C16 |
43 | Lê Văn Ph. | Nam | 67 | 29/3/2011 | 6/4/2011 | 7665/C16 |
44 | Nguyễn Thu H. | Nữ | 48 | 27/4/2011 | 8/5/2011 | 10740/C18 |
45 | Nguyễn T Minh H. | Nữ | 52 | 12/5/2011 | 26/5/2011 | 12387/c17 |
46 | Nguyễn Thị K. | Nữ | 62 | 15/5/2011 | 2/6/2011 | 13761/C16 |
47 | Phạm Đình L. | Nam | 71 | 18/5/2011 | 27/5/2011 | 12936/C16 |
48 | Bùi Thị Phương T. | Nữ | 65 | 20/5/2011 | 16/6/2011 | 13141/C16 |
49 | Đỗ Thị L. | Nữ | 80 | 12/6/2011 | 26/6/2011 | 15821/C16 |
50 | Lê Thị Q. | Nữ | 49 | 4/7/2011 | 13/7/2011 | 18357/C45 |
51 | Nguyễn Thị Nh. | Nữ | 57 | 6/7/2011 | 20/7/2011 | 18639/C18 |
52 | Vũ Văn A. | Nam | 81 | 21/8/2011 | 1/9/2011 | 24174/C18 |
53 | Nguyễn Việt Ch. | Nam | 78 | 8/9/2011 | 19/9/2011 | 26389/C16 |
54 | Nguyễn Chí H. | Nam | 64 | 11/9/2011 | 21/9/2011 | 26653/C16 |
55 | Nguyễn Đức H. | Nam | 67 | 12/9/2011 | 21/9/2011 | 26678/C16 |
56 | Nguyễn Thị H. | Nữ | 59 | 16/9/2011 | 28/9/2011 | 27302/c16 |
57 | Trần Thị Bích L. | Nữ | 56 | 16/9/2011 | 28/9/2011 | 27288/C16 |
58 | Vũ Đình Ph. | Nam | 59 | 21/11/2011 | 29/11/2011 | 34892/C16 |
59 | Chu Thị Th. | Nữ | 67 | 28/11/2011 | 5/12/2011 | 35745/C16 |
60 | Nguyễn Văn Ch. | Nam | 68 | 28/11/2011 | 5/12/2011 | 35706/C16 |
61 | Trần Thị D. | Nữ | 58 | 29/11/2011 | 7/12/2011 | 35787/C16 |
62 | Trần Thị Minh Ng. | Nữ | 57 | 15/12/2011 | 28/12/2011 | 37704/C16 |
63 | Nguyễn Bích Đ | Nữ | 47 | 4/1/2012 | 12/1/2012 | 191/C16 |
Nguyễn Quang T. | Nam | 41 | 13/1/2012 | 1/2/2012 | 1072/c16 | |
65 | Phan Thanh T. | Nam | 65 | 17/1/2012 | 14/2/2012 | 1368/C16 |
66 | Đỗ Xuân Tr. | Nam | 75 | 30/1/2012 | 14/2/2012 | 2039/C16 |
67 | Phạm Văn T. | Nam | 40 | 19/2/2012 | 29/2/2012 | 3924/C17 |
68 | Phạm Thị L. | Nữ | 59 | 20/2/2012 | 1/3/2012 | 3976/C18 |
69 | Nguyễn Văn D. | Nam | 77 | 26/2/2012 | 5/3/2012 | 4693/C17 |
70 | Văn Thị Th. | Nữ | 64 | 5/3/2012 | 23/3/2012 | 5437/C16 |
71 | Hoàng Văn M. | Nam | 51 | 8/3/2012 | 18/3/2012 | 5771/C18 |
72 | Vương Thị Th. | Nữ | 54 | 19/3/2012 | 27/3/2012 | 6927/C16 |
73 | Đỗ Thị T. | Nữ | 43 | 3/4/2012 | 27/4/2012 | 8624/C17 |
74 | Nguyễn Thị Kiều H. | Nữ | 50 | 19/4/2012 | 27/4/2012 | 10508/C17 |
75 | Lê Xuân Ph | Nam | 62 | 27/4/2012 | 21/5/2012 | 11417/C18 |
76 | Chu Thị X. | Nữ | 64 | 7/5/2012 | 21/5/2012 | 12527/C16 |
77 | Vũ Đình T. | Nam | 58 | 10/5/2012 | 25/5/2013 | 12781/C48 |
78 | Nguyễn Quang Nh. | Nam | 75 | 10/5/2012 | 25/5/2012 | 12741/C17 |
79 | Mai Văn Th. | Nam | 54 | 20/5/2012 | 7/6/2012 | 13995/C18 |
80 | Đỗ Minh Q. | Nam | 52 | 6/6/2012 | 16/7/2012 | 16114/C17 |
81 | Đào Thị T. | Nữ | 69 | 22/6/2012 | 4/7/2012 | 18197/C16 |
82 | Dương Minh Ch. | Nam | 85 | 26/6/2012 | 12/7/2012 | 18669/C16 |
83 | Trần Thị C. | Nữ | 79 | 27/6/2012 | 9/7/2012 | 18837/C45 |
84 | Nguyễn Văn Đ | Nam | 40 | 27/6/2012 | 13/7/2012 | 18735/C16 |
85 | Vũ Khắc M. | Nam | 45 | 9/7/2012 | 23/7/2012 | 20226/C16 |
86 | Nguyễn Đăng D. | Nam | 54 | 10/7/2012 | 18/7/2012 | 20346/C18 |
87 | Hoàng Thị Th. | Nữ | 83 | 14/7/2012 | 25/7/2012 | 21049/C45 |
88 | Ngô Thị L. | Nữ | 62 | 16/7/2012 | 6/8/2012 | 21141/C16 |
89 | Trần Đức Ch. | Nam | 29 | 27/7/2012 | 14/8/2012 | 22653/C16 |
90 | Đặng Thị Bích D. | Nữ | 63 | 5/8/2012 | 13/8/2012 | 23760/C16 |
91 | Ngô Trúc L. | Nam | 65 | 19/8/2012 | 26/8/2012 | 25798/C17 |
92 | Lê Thị H. | Nữ | 56 | 20/8/2012 | 28/8/2012 | 25716/C17 |
93 | Phùng Thị Minh Th. | Nữ | 79 | 23/8/2012 | 4/9/2012 | 26172/C16 |
94 | Nguyễn Thị D. | Nữ | 67 | 30/8/2012 | 7/9/2012 | 27089/C17 |
95 | Trịnh Thị Ch. | Nữ | 76 | 5/9/2012 | 17/9/2012 | 27706/C18 |
96 | Mai Tuấn A. | Nam | 45 | 9/9/2012 | 18/9/2012 | 28168/C17 |
97 | Bùi Trung H. | Nam | 62 | 10/9/2012 | 5/10/2012 | 28267/C20 |
Đỗ Thị L. | Nữ | 58 | 18/9/2012 | 25/9/2012 | 29348/C18 | |
99 | Nguyễn Hữu Đ | Nam | 58 | 1/10/2012 | 11/10/2012 | 30880/C16 |
100 | Nguyễn Trọng Kh. | Nam | 54 | 3/10/2012 | 16/10/2012 | 31514/C17 |
101 | Doãn Thị U. | Nữ | 83 | 3/10/2012 | 16/10/2012 | 3125/C18 |
102 | Nguyễn Thị Thu H. | Nữ | 50 | 4/10/2012 | 12/10/2012 | 31381/C16 |
103 | Nguyễn Ngọc V. | Nam | 66 | 11/10/2012 | 25/10/2012 | 32247/C17 |
104 | Ngô Đức Tr. | Nam | 75 | 12/10/2012 | 13/11/2012 | 32368/C20 |
105 | Lê Ph. | Nam | 49 | 14/10/2012 | 3/11/2012 | 32526/C18 |
106 | Phạm Văn Th. | Nam | 55 | 23/10/2012 | 12/11/2012 | 33710/C16 |
107 | Nguyễn Văn M. | Nữ | 76 | 1/11/2012 | 23/11/2012 | 34730/C48 |
108 | Phạm Văn D. | Nam | 54 | 5/11/2012 | 15/11/2012 | 35162/C15 |
109 | Đỗ Thị V. | Nữ | 54 | 7/11/2012 | 14/11/2012 | 35670/C17 |
110 | Phạm Văn Q. | Nam | 38 | 8/11/2012 | 22/11/2012 | 35667/C16 |
111 | Nguyễn Văn K. | Nam | 63 | 9/11/2012 | 27/11/2012 | 35792/C17 |
112 | Nguyễn Văn Ch. | Nam | 71 | 17/11/2012 | 3/12/2012 | 36707/C16 |
113 | Nguyễn Thị H. | Nữ | 72 | 2/12/2012 | 28/12/2012 | 39728/C16 |
114 | Trần Thị S. | Nữ | 46 | 3/12/2012 | 11/1/2013 | 178/C16 |
115 | Tăng Thị L. | Nữ | 55 | 4/12/2012 | 21/12/2012 | 38734/C17 |
116 | Nguyễn Văn T. | Nam | 48 | 5/12/2012 | 21/12/2012 | 38944/C16 |
117 | Phạm Minh T. | Nam | 70 | 10/12/2012 | 20/12/2012 | 39472/C16 |
118 | Lê Văn Tr. | Nam | 73 | 11/12/2012 | 24/12/2012 | 39577/C18 |
119 | Đàm Viết M. | Nam | 46 | 18/12/2012 | 27/12/2012 | 40409/C16 |
120 | Nguyễn Sĩ B. | Nam | 23 | 18/12/2012 | 27/12/2012 | 40433/C16 |
121 | Trần Thị L. | Nữ | 47 | 21/12/2012 | 2/1/2013 | 40846/C16 |
122 | Bùi Đức H. | Nam | 44 | 25/12/2012 | 2/1/2013 | 41193/C16 |
123 | Vũ Văn B. | Nam | 71 | 4/1/2013 | 24/1/2013 | 405/C16 |
124 | Bùi Hữu O. | Nam | 83 | 8/1/2013 | 23/1/2013 | 788/C16 |
125 | Đặng Thị M. | Nữ | 55 | 14/1/2013 | 30/1/2013 | 2152/C16 |
126 | Lê Thị C. | Nữ | 45 | 14/1/2013 | 30/1/2013 | 1410/C16 |
127 | Ngô Văn Ng. | Nam | 60 | 25/1/2013 | 4/2/2013 | 2691/c18 |
128 | Bùi Đức Th. | Nam | 31 | 11/2/2013 | 26/2/2013 | 3957/C17 |
129 | Võ Văn Th. | Nam | 40 | 18/2/2013 | 4/3/2013 | 4939/C17 |
130 | Bùi Thị T. | Nữ | 75 | 26/2/2013 | 11/3/2013 | 5244/C16 |
131 | Hoàng Văn H. | Nam | 72 | 2/3/2013 | 11/3/2013 | 5660/C17 |
Dương Quang S. | Nam | 47 | 14/3/2013 | 25/3/2013 | 7175/c17 | |
133 | Lê Thị Ch. | Nữ | 73 | 21/3/2013 | 29/3/2013 | 8083/C17 |
134 | Kiều Hồng T. | Nam | 65 | 21/3/2013 | 30/3/2013 | 8043/C16 |
135 | Nguyễn Văn L. | Nam | 55 | 23/3/2013 | 20/5/2013 | 8244/C25 |
136 | Vũ Tiến O. | Nam | 46 | 24/3/2013 | 8/4/2013 | 8912/C16 |
137 | Trần Bá Ch. | Nam | 76 | 1/4/2013 | 27/4/2013 | 9288/C18 |
138 | Phan Văn Tr. | Nam | 60 | 5/4/2013 | 16/4/2013 | 9929/C16 |
139 | Trần Thị B. | Nữ | 65 | 8/4/2013 | 13/4/2013 | 10173/C16 |
140 | Bùi Thị T. | Nữ | 68 | 9/4/2013 | 17/4/2013 | 10419/C16 |
141 | Nguyễn Văn S. | Nam | 54 | 3/5/2013 | 21/5/2013 | 13142/c18 |
142 | Nguyễn Thị Ng. | Nữ | 34 | 7/5/2013 | 16/5/2013 | 13552/C16 |
143 | Đỗ Thị T. | Nữ | 53 | 14/5/2013 | 22/5/2013 | 14516/C16 |
144 | Vũ Quỳnh H. | Nữ | 50 | 16/5/2013 | 24/5/2013 | 14841/C17 |
145 | Hoàng Thị Đ. | Nữ | 58 | 16/5/2013 | 11/6/2013 | 14797/C17 |
146 | Nguyễn Thị T. | Nữ | 77 | 19/5/2013 | 30/5/2013 | 14281/C18 |
147 | Tạ Duy T. | Nam | 68 | 27/5/2013 | 13/6/2013 | 16099/C16 |
148 | Nguyễn Thị Ph. | Nữ | 61 | 11/6/2013 | 19/6/2013 | 18158/C16 |
149 | Đặng Văn T. | Nam | 58 | 11/6/2013 | 20/6/2013 | 18150/C16 |
150 | Tống Thị H. | Nữ | 56 | 24/6/2013 | 26/7/2013 | 19742/C17 |
151 | Nguyễn Văn B. | Nam | 61 | 2/7/2013 | 17/7/2013 | 20945/C16 |
152 | Mai Thị V. | Nữ | 47 | 2/7/2013 | 15/7/2013 | 20874/C16 |
153 | Nguyễn Thị H. | Nữ | 49 | 22/7/2013 | 2/8/2013 | 23546/c17 |
154 | Hoàng Thị Th. | Nữ | 84 | 14/12/2013 | 9/1/2014 | 42137/C17 |
155 | Mai Thị H. | Nữ | 52 | 26/7/2013 | 5/8/2013 | 24250/C16 |
156 | Tạ Bá T. | Nam | 54 | 5/8/2013 | 20/8/2013 | 25409/c17 |
157 | Phạm Thị H. | Nữ | 66 | 18/8/2013 | 10/9/2013 | 27205/C16 |
158 | Trịnh Thị N. | Nữ | 65 | 19/8/2013 | 28/8/2013 | 27403/C45 |
159 | Đinh Văn Th. | Nam | 38 | 20/8/2013 | 27/8/2013 | 27472/c17 |
160 | Nguyễn Thị M. | Nữ | 56 | 21/8/2013 | 11/9/2013 | 27682/C17 |
161 | Nguyễn Văn Đ. | Nam | 65 | 21/8/2013 | 12/9/2013 | 27605/C17 |
162 | Bùi Trí Ch. | Nam | 68 | 30/8/2013 | 17/9/2013 | 28855/C17 |
163 | Lâm Thị T. | Nữ | 59 | 30/8/2013 | 15/9/2013 | 29845/C17 |
164 | Vũ Đông B. | Nam | 52 | 3/9/2013 | 11/9/2013 | 29330/c17 |
165 | Nguyễn Thị Th. | Nữ | 47 | 12/9/2013 | 25/9/2013 | 30453/C16 |